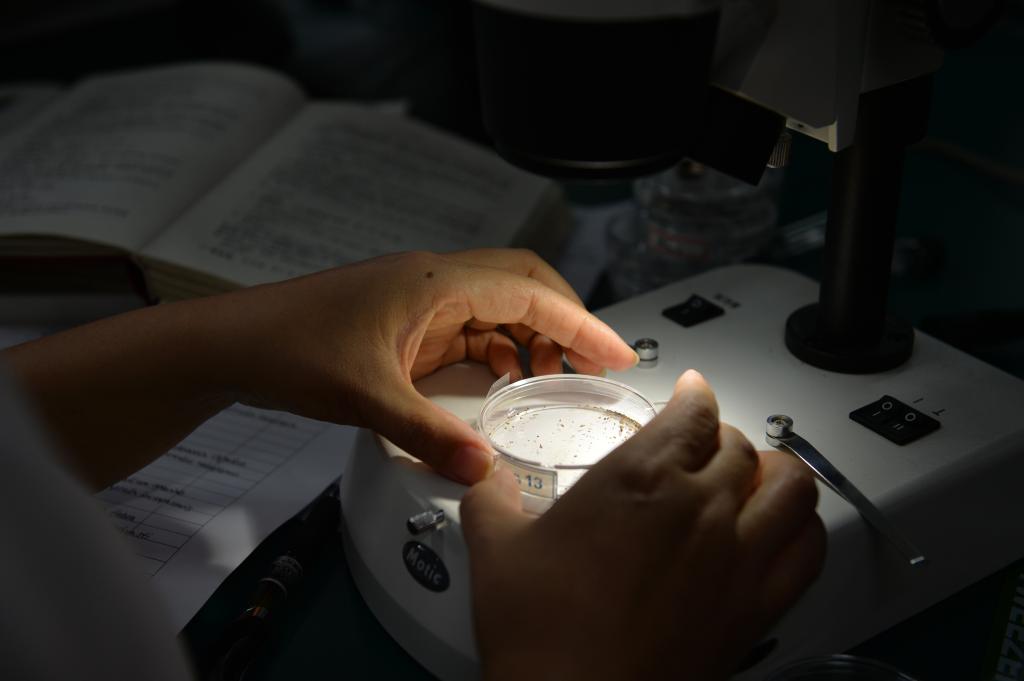

一颗杂草荒废百亩良田,一只小虫毁灭数片森林,这并非危言耸听。生态安全背景之下,“斗草捉虫”不再是“儿戏”,而成为知识性、专业性极强的职业技能,是国内植物保护、森林保护和进出境植物检疫工作者履职尽责、依法施检的职业基础。
9月25日,为期2天的有害生物检疫鉴定技能竞赛决赛在亚洲色吧
圆满落幕,从40名闯入决赛的“高手”中寻找发掘有害生物的“顶级捕手”。

此次有害生物检疫鉴定技能竞赛是2018年江苏省十大职工职业技能竞赛之一,也是江苏首次举办有害生物鉴定方面的专业竞赛。竞赛由江苏省总工会、江苏省人力资源社会保障厅主办,南京海关承办,亚洲色吧
协办,向江苏全省从事植物检疫、植物保护、森林保护等相关岗位的一线工作人员吹响集结号,通过层层选拔,汇集了江苏13个设区市40名选手参加最终角逐。
决赛包括理论考试和现场操作技能考核两个部分。理论考试主要测试选手对植物保护学、森林保护学、植物学和植物检疫学基础理论和有害生物分类鉴定基础知识的掌握情况。现场操作分为昆虫、杂草和线虫三个项目,标本鉴定、标本制作两个环节,最考验选手的实战能力。

对于植物保护和检疫的一线工作者,能否在短时间内分辨鉴别有害生物的“身份”,是他们的核心职业素养。标本鉴定环节,提供林业昆虫、仓储昆虫、农业昆虫、水生杂草、旱生杂草、农业线虫和林业线虫等各类有害生物标本,要求选手在给定时间内准确鉴定到种。这并非易事。动物、植物、微生物构成的自然生物圈,物种数量庞大,形态复杂,仅已知的昆虫种类就达100余万种。
2017年,江苏进口粮食3583万吨,进口木材2683万立方米,成千上万的“偷渡客”随之而来。连云港海关的参赛选手潘杰说:“把好国门生物安全关,既要看的准,不能让一只‘害虫’进来;也要判的快,不能影响通关速度或者因为误判增加企业的处理成本。”而如何准确鉴定病虫害种类,避免过度使用农药或盲目使用农药,也是现代化农业工作者所面临重大现实问题之一。
竞赛活动办公室主任、南京海关动植物检疫监管处处长吴新华表示,标本制作看起来风平浪静,实际则是最能体现选手实力一个环节。标本制作要求选手通过鉴定特征解剖、特征照片拍摄制作实物标本和数字标本,直接考核选手的“手上功夫”。“昆虫项目”中的豆象个体只有1-2毫米,却要从中解剖出鉴定用的虫体器官,其难度不亚于医生的精细手术;“线虫项目”培养皿中的“液体”几乎无色透明,裁判告诉记者里面实际有大量线虫,在显微镜下,肉眼难以发现的小小线虫一团团扭来扭去。已造成154万株松树死亡,对我国松林产生致命性伤害的“松材线虫”就是线虫家族成员。在有限的时间内,对这些“微生物”辨明正身,然后再制成标本,需要心灵与手巧,更需耐心和毅力。
来自张家港植保植检站的选手殷茵说,这个工作既是技术活又是体力活,在实验室里一坐就是一整天。一天下来,腰酸背痛,眼睛发花。也正是通过潜心钻研和不断实践,造就了这些选手们知识背景扎实、操作技能精湛。比赛现场,选手们均在规定时间内出色完成了鉴定和标本制作任务。

以赛增技、以赛促能,有害生物检疫鉴定技能竞赛是优秀人才竞技和展示的舞台,也成为激发更多植物保护、植物检疫工作者精益求精、苦练本领的加速器。据省总工会劳动与经济工作部李润芝副部长介绍,竞赛前六名选手将由省总工会、省人力资源和社会保障厅分别授予“江苏省五一创新能手”“江苏省技术能手”称号,获得第一名的选手经综合考察合格后,还可按程序申报“江苏省五一劳动奖章”。
生态文明被纳入“五位一体”总体布局,保护好中国的生物安全和生态安全备受关注。南京海关副关长王续刚介绍,江苏是经济强省、开放大省,粮食、木材等初级农产品进口量一直高居全国前列,有害生物传入风险日益增高。仅2017年,南京海关在江苏口岸就截获各类有害生物202种25744种次,其中不乏地中海实蝇、大家白蚁、松材线虫、一枝黄花等“著名”有害生物以及圆角木蠹象、阿帕奇齿小蠹等全国首次发现的检疫性有害生物。如何更有效地防范物种资源流失和外来物种入侵、保护国门生物安全成为新海关人面临的重要课题。
通过竞赛,加强农林、海关、科研院所等相关部门的协作以及呼吁全社会共同关注生态安全也是此次比赛的题中之义。亚洲色吧
党委副书记盛邦跃说,南农大为植物检疫事业提供了强大的技术和人才支持,也将以此次竞赛为契机,发挥优势,广泛宣传,营造共建美丽生态家园的良好氛围。